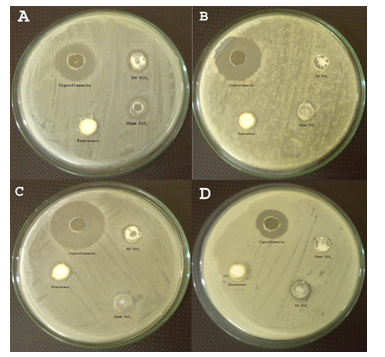

Int J Pharm Pharm Sci, Vol 6, Issue 11, 396-400Original Article
PHYSIOCHEMICAL INVESTIGATION AND BIOVALUATION OF TiO2 NANOCRYSTALS SYNTHESIZED BY CHEMICAL AND GREEN ROUTE
SHAKILA BANU Aa, VIVEK VISHNU Aa, JAMUNA KSa, GINO A KURIANa*
aSchool of Chemical and Biotechnology, SASTRA University, Thanjavur, Tamil Nadu.
Email: ginokurian@hotmail.com
Received: 29 Aug 2014 Revised and Accepted: 01 Oct 2014
ABSTRACT
Objectives: In this present work, we have compared titanium dioxide nanocrystals synthesized by both chemical method and biological method from Titanium tetra isopropoxide as precursor. The biological method was performed by using the aqueous root extract of Desmodium gangeticum and further they were characterized and checked for their biological activities.
Methods: The TiO2 nanocrystals were characterized by UV-Visible spectrophotometer for its maximum SPR peak, X-ray diffractometry for its crystalline size and shape, Fourier transform infrared spectroscopy for functional entity identification and Zeta potential for its colloidal stability. Antioxidant assay and antimicrobial test were performed to evaluate its biological behaviour.
Results: The nanocrystals synthesized by biological method were found to have higher antioxidant potential, antimicrobial activity and phenolic content than the chemically synthesized ones. Evaluation of toxicity in cell line LLC-PK1 suggests that TiO2nanocrystals synthesized by green route is less toxic.
Conclusion: Green synthesized TiO2 nanocrystals were seen to have less toxicity than the chemical method in showing their biocompatibility nature which can be applied in the field of medical science.
Keywords: Antimicrobial, Cytotoxicity, Desmodium gangeticum, Green synthesis, Phytoconstituents, TiO₂ Nanocrystals.
INTRODUCTION
Nanotechnology is an interdisciplinary area of science which has been attained worldwide recognition with huge momentum to result in nano revolution. An important area in nanotechnology deals with the synthesis of nanocrystals, which has encountered immense progress due to innumerable applications in recent decades. Nanoparticles are generally synthesized by Physical, Chemical or biological routes.
The use of plants in the synthesis of nanoparticles has become one of the popular alternatives to conventional methods. Plant mediated synthesis of nanoparticles is conferred due to the presence of biomolecules such as proteins, amino acids, vitamins, polysaccharides, polyphenols, terpenoids, and organic acids such as citrates etc. Present in the plants as their phytochemicals. Apart from mediating the synthesis, these molecules also stabilize the nanoparticles formed with the desired size and shape [1][2].
Metal oxide nanoparticles have smaller size and larger surface area per volume, which is responsible for their unique properties such as mechanical strength, thermal durability, and magnetic, electronic and catalytic activity. Among the various metal oxide nanoparticles, titanium dioxide nanoparticles have wide applications in air and water purification due to their potential oxidation strength, high photo stability and non-toxicity.
Desmodium gangeticum (Fabaceae family) (DG) is a small shrub of the tropical regions which is used in an Indian indigenous medicine as febrifuge, digestive, anticatarrhal, antiemetic and as anti-inflammatory agent[3]. Crude extracts, various fractions (ethanol, methanol, aqueous) and isolated compounds of Desmodium gangeticum showed a wide spectra of in vitro [4] and in vivo pharmacological activity including protection against ischemic reperfusion injury [5]. The constituents namely gangetin, quercetin, genistein and kaempferol are reported to be anticancerous agents. Desmodium gangeticum was reported to have significant antioxidant potential and has potent antiapoptotic phytoconstituents. Its phytoconstituents namely flavanoids, isoflavanoid glycoside and polyphenolic compounds are known to be good antioxidant agents [6].
In our laboratory, we had already synthesized TiO2 nanocrystals using Desmodium gangeticum root aqueous extract. This manuscript deals with the comparative study ofTiO2 nanocrystals prepared by both chemical and green routes.
MATERIALS AND METHODS
Materials
Titanium tetraisopropoxide [Ti (OCH (CH3)2)4], Isopropanol (C3H7OH), Acetic acid (CH3COOH), DPPH(2,2-Diphenyl 1-picrylhydrazyl), Folin- Ciocalteu reagent, Sodium carbonate (Na2CO3), Potassium hexacyanoferrate (Na4Fe(CN)6), TCA (Trichloroacetic acid), riboflavin, nitrobluetetrazolium (NBT) and ethanol were purchased from Sigma Aldrich, India. Muller Hinton Agar, Agar was purchased from Hi Media, India and LLC-PK1 cell line was purchased from NCCS, Pune, India. All the chemicals were used without any further purification.
Preparation of aqueous DG extract
Desmodium gangeticum (Linn) DC (DG) roots were collected from St. Berchmans College Botanical Garden, Changanassery, and Kerala, India and authenticated by HOD, Botany Department, SB College. The voucher of the specimen was kept for reference. Roots were washed thoroughly with tap water and dried in the shade. Dried roots were cut into small pieces and ground coarsely using pulverizer. Soxhlet extraction was then performed to obtain the crude aqueous extract which is stored in the refrigerator for further use.
Synthesis of titanium dioxide nanocrystals
By chemical method
TiO₂ nanocrystals were prepared by the sol gel technique. Metal precursor Titanium tetraisopropoxide (2 mL) was added to solvents Isopropanol (2 mL) and acetic acid (1 mL). It was rapidly stirred at room temperature and distilled water was added drop wise to obtain sol gel transformation. It was then air dried and calcined at 450°C for 30 minutes to obtain nanocrystalline TiO₂.
By using aqueous DG extract
Metal precursor Titanium tetraisopropoxide (2 mL) was added to aqueous root extract of DG (2 mL) and stirred well to observe sol-gel transformation. It was then air dried and calcined at 450°C for 30 minutes to obtain nanocrystalline TiO₂.
Characterization of titanium dioxide nanocrystals
UV visible spectrophotometer was used to carry out preliminary characterization of nanocrystalline TiO₂. Absorption spectra were recorded in the range between 200 to 900 nm. FTIR spectral analysis was performed to identify the functional groups and the nature of the chemical environment around the nanocrystalline TiO₂. The spectrum was recorded using the Perkin Elmer spectrum 1instrument in a diffuse reflection mode operating at a resolution of 4 cm-1between 4000 and 400 cm-1. XRD pattern of TiO₂ nanocrystal was recorded in a wide range of Bragg angles2θ from 10°C to 80°Cat a scanning rate of 2° min−1. Measurement was carried out on a Rigaku instrument operating at a voltage of 40 kV and a current of 30 mA with CuKα at a wavelength of 1.5405 Å. The average grain size was calculated using Debye-Scherrer's formula. Zeta potential of the TiO2 nanocrystals in an aqueous phase was measured using Zetasizer Nano S90 from Malvern Instrument Ltd. The electric field added on the suspension was controlled by the cell voltage of Zetacompact Z8000 model and was fixed at 80V. The Henry equation is then used to calculate the zeta potential.
Antioxidant assays
The free radical scavenging assays are studied for the synthesized TiO2 nanocrystals by DPPH (2, 2-Diphenyl-2-picrylhydrazyl) assay and superoxide radical scavenging assay[7]. The nanocrystals synthesized by both green and chemical routes were taken in different concentrations (1000 to 125 µg/ml) along with the precursor (Titanium tetraisopropoxide) and DG extract for the study. The absorbance was measured at 518 nm and 560 nm respectively for both the assays. The total phenolic content was also studied for the nanocrystals by Folin- Ciocalteu assay [8] and absorbance was measured at 765 nm.
Antimicrobial assay
Agar well diffusion method was followed to determine the antimicrobial activity (Murray et al, 1995) [9]. The strains chosen were Bacillus subtilis (2413), Staphylococcus aureus MTCC (3160), Staphylococcus aureusE1 (9886) and Escherichia coli (574). Muller Hinton agar plates were prepared by adding Muller Hinton agar (3.8 mg) and Agar Agar (1.7 mg) in distilled water (100 mL) followed by autoclaving. The plates were swabbed with the respective bacteria and four wells were bored using the sterile cork borer. Stock solutions (1 mg/mL) of precursor (Titanium tetraisopropoxide), nanocrystalline TiO2 (both chemical and green), and antibiotic (Ciprofloxacin) were prepared in distilled water. Ciprofloxacin is used as the positive control. 100 µL of each sample was added into the respective well. The plates were incubated at 37°C for 18 hours and the zone of inhibition was observed.
Toxicology
Cytotoxicity of TiO2nanocrystals was determined by lactate dehydrogenase (LDH) activity. LDH assay determines the release of cytoplasmic enzyme Lactate dehydrogenase to the culture media due to the damage of cells caused by nanoparticle (1 mg/mL). Cells were cultured in 96 well culture plates and incubated for 24 hours. After incubation, the medium was removed and the cells were washed with PBS. The cells were treated with synthesized TiO2 nanocrystal (both chemical and green), DG and precursor Titanium tetraisopropoxide. After 24 hours of treatment, 50 µL of culture supernatant was collected and incubated with reaction mixture containing NAD+, lactate and Phosphate buffer (0.2 M, pH 7.4), each 50 µL. The LDH catalyzed reaction is measured at 340 nm.
Statistical analysis
In biological evaluation assays like DPPH, superoxide scavenging, total phenol and cytotoxicity, the data signify, mean ± SD of three samples and are representatives of three independent experiments. The data were subjected to an analysis of variance (ANOVA) by Graph Pad prism 5.

Fig. 1: Characterization of TiO2 nanocrystals by UV, FTIR and XRD
RESULTS AND DISCUSSION
Characterization
Physicochemical characterization of the synthesized TiO2 nanoparticle was done by the methods such as UV – Visible, FTIR, XRD and Zeta potential. Further nanocrystals synthesized were checked for their antioxidant, antimicrobial and cytotoxicity to determine its biological activity.
UV-visible spectroscopy
The absorption spectrum recorded for TiO2 nanocrystals is shown in Fig. 1A and 1B. UV–vis spectral analysis of DG synthesized TiO2 nanocrystal shows surface plasmon resonance maximum absorption peak at 380 nm and chemically synthesised TiO2nanocrystal shows maximum absorption at 320 nm. The sharp band of absorption suggests the spherical shape of synthesized nanocrystals. Metallic nanocrystals can be synthesized by reducing metal ions, and it is believed that the natural material extract or chemicals can act as reducing agents for the synthesis of nanocrystals.
In general, chemically synthesized nanocrystals require capping agents to control its particle size, and it depends on the molar concentration of the capping agent. However, in the synthesized TiO2 nanocrystal, in this study, no additional capping agent was used. In order to get the nature of the capping agent present, we analysed the particle for different functional groups with FTIR.
FTIR (Fourier transform infrared spectroscopy)
The interaction between different species and changes in chemical composition of the mixture was investigated by FTIR. The IR spectra were recorded in the range of 400-4000 cm-1. Fig 1C shows the IR spectra of DG synthesized TiO2nanocrystal. IR spectrum covers an absorption band at 3854.43 cm-1, 3690.97 cm-1, 3398.73 cm-1, 1629.44 cm-1, 1400.28 cm-1 and 639.14 cm-1. Strong absorption peaks at 3854.43 cm-1, 3690.97 cm-1, and 3398.73 cm-1 refers to O-H stretch of water and phenolic compounds which are present in the FTIR spectrum of DG extract too that indicates a strong interaction between DG and DG synthesized TiO2nanocrystals. The peak at 3398.73 cm-1 shows the normal polymeric O-H stretch and 1629.44 cm-1 shows the aryl substituted C=C stretching. The peak at 1400.28 cm-1 refers to C=H stretching and 639.14 cm-1 refers to Ti-O stretching [10].
Fig 1D shows the IR spectra of chemically synthesized TiO2 nanocrystals. IR spectrum covers an absorption band at 660.25 cm-1, 1445.58 cm-1, 1629.44 cm-1, 3367.92 cm-1 and 3850.69 cm-1. Absorption peak at 3850.69 cm-1 refers to O-H stretch of water and phenolic compounds. The peak at 3367.92 cm-1 shows the normal polymeric O-H stretch and the aryl substituted C=C stretching is shown by the peak at 1629.44 cm-1. The peaks at 1445.58 cm-1refers to C=H stretching and 660.25 cm-1 refers to Ti-O stretching [10]. Similar peaks were observed in TiO2nanocrystals synthesised by the green route.
XRD (X-ray diffraction)
The XRD pattern of DG was synthesized and chemically synthesized TiO₂ is shown in fig. 1E. In the DG synthesized TiO₂ sharp diffraction peaks emerge at 2θ angles of 25.2°, 37.8°, 47.9°, 53.59ο and 63.26° suggesting the anatase phase of nanocrystalline TiO2. The average grain size calculated by using Scherrer equation was 0.7 nm. The peaks at scattering angles (2θ) of 25.2ο, 37.8°,47.9°, 53.59ο and 63.26° corresponds to Bragg’s reflection from 101, 004, 200, 105 and 204 crystal planes, respectively (JCPDS files # 21-1272)[11].
In the chemically synthesized TiO₂ (fig. 1F) also, sharp diffraction peaks emerge at 2θ angles 25.2°, 37.8°, 47.9°, 53.59ο and 63.26° suggesting the anatase phase of nanocrystalline TiO2 and Bragg’s reflection from 101, 004, 200, 105 and 204 crystal planes, respectively (JCPDS files # 21-1272) [11]. The average grain size was calculated to be 2.59 nm.
Zeta potential
The surface charge of nanoparticles gives information on their colloidal stability. Zeta potential is used to determine the surface charge of nanoparticles in solutions. In the present study, TiO2 nanocrystals prepared by chemical route (fig. 2A and 2B) showed the hydrodynamic diameter of 1065 nm with PDI of 0.276, where as in the nanocrystals prepared by green route (fig. 2C and 2D) showed hydrodynamic diameter as 1016 nm with PDI of 0.320. The hydrodynamic diameter gives information of the inorganic core along with any coating material and the solvent layer attached to the particle as it moves due to Brownian motion. Due to vander Waal’s inter-particle attractions, dispersions with a low zeta potential value will eventually aggregate. The zeta potential of TiO2 nanocrystals synthesized by green and chemical route was 14.6 mV and 36.4 mV respectively, indicating its stability.

Fig. 2: Zeta potential spectra of TiO2 nanocrystals

Fig. 3: Free radical scavenging activity of TiO2 nanocrystals
Antioxidant assays
Antioxidant capacity is measured using assays based on hydrogen atom transfer reactions and electron transfer reactions. The DPPH scavenging potential and super oxide scavenging was analysed to determine the antioxidant potential of TiO₂ nanocrystals. Dose dependant quenching was observed in both the assays as showed in fig. 3A and 3B, indicating the potential to be an effective antioxidant. Thus the higher antioxidant potential measured by DPPH and Super oxide scavenging technique in TiO₂ nanocrystals prepared by green route suggests the presence of additional moiety in the nanocrystals that participates in free radical scavenging action.
In this connection, we measure the total phenol content in the synthesized nanocrystals (fig. 4). Nanocrystalline TiO₂ synthesized by the green route was found to possess the greater phenolic content when compared to the chemically synthesized one. The total phenolic content present in green and chemical nanocrystalline TiO₂ was found to be 0.724 mg/mL and 0.459 mg/mL of ascorbic acid equivalent respectively. Evidences from the previous study indicate that phenolic compounds have O2− scavenging activity. Therefore, higher superoxide scavenging activity in TiO2 nanocrystals synthesized by green route over the one prepared by chemical route reconfirm the superior antioxidant potential.

Fig. 4: Total phenol content of TiO2 nanocrystals
Fig. 5: Antimicrobial activity of TiO2 nanocrystals
Antimicrobial assay was carried out using the strains Bacillus subtilis MTCC 2413 (Gram positive), Staphylococcus aureus MTCC 3160 (Gram positive), Staphylococcus aureusE1 (Gram positive), Escherichia coli MTCC 574 (Gram negative). The zone of inhibition was measured using the software Image J (National Institutes of Health) (Table 1). In comparison with the precursor Titanium tetraisopropoxide and chemically synthesized TiO2nanocrystals, the green synthesised ones exhibit greater antimicrobial activity against Gram positive organisms (fig. 5). The metal oxides carry a positive charge while the microorganisms carry negative charge; this causes electromagnetic attraction between microorganisms and the metal oxides which leads to oxidization and finally the death of microorganism [12]. Nanomaterials also could deactivate the cellular enzymes and DNA by coordinating to electron-donating groups, such as thiols, carbohydrates, amides, indoles, and hydroxyls. They cause pore in bacterial cell walls, leading to increase in permeability and cell death [13].
Table 1: Antibacterial activity of TiO2 nanocrystals; Zone of inhibition was given in mm.
| Strains | Green TiO2 NP | Chemical
TiO2 NP |
Control | [Ti(OCH(CH3)2)4] |
| Bacillus subtilis MTCC (2413) | 12.570 | 7.849 | 16.024 | 9.653 |
| Escherichia coli MTCC (574) | 8.166 | - | 25.224 | 9.249 |
| Staphylococcus aureus MTCC (3160) | 12.94 | 4.23 | 20.320 | 9.127 |
| Staphylococcus aureusE1 (9886) | 11.290 | - | 29.102 | 11.132 |
Antimicrobial activity
Toxicology
Toxicity was determined using lactate dehydrogenase (LDH) assay in LLC-PK1 epithelial cell line from pig, which determines the release of cytoplasmic enzyme lactate dehydrogenase from the membrane due to cell damage. The present study evaluates the toxicity of TiO2 nanocrystals prepared by both green and chemical routes the result of the LDH assay (fig. 6) demonstrates that the nanocrystalline TiO₂ synthesised by green method is less harmful to the cells in comparison with DG extract and chemically synthesized TiO2 nanoparticle. Thus it could be used for further biological applications.

Fig. 6: LDH release into the medium by TiO2 nanocrystals
*Values are represented as mean±S.D. (n=4)
CONCLUSION
The present study reports comparison between TiO₂ nanocrystals synthesized by chemical and green (using Desmodium gangeticum aqueous root extract) means. We prepared stable nanocrystal aggregates with spherical geometry. The nanocrystals synthesised by green method was found to be safer compared to chemically synthesised particle as it shows no significant damage against LLC-PK1 epithelial cells. Further, the presence of phenolic content and the high reducing property not only render antioxidant property, but also make the green synthesized TiO2 nanocrystalsa good antimicrobial agent.
CONFLICT OF INTEREST
There is no conflict of Interest.
ACKNOWLEDGEMENT
The authors are thankful to Dr. P. Brindha, Dean, CARISM (Centre for Advanced Research in Indian Systems of Medicine) for the generous support. The authors also acknowledge financial assistance from the management of SASTRA University, Thanjavur.
REFERNECES
- Collera-Zúñiga O, Garcı́a Jiménez F, Meléndez Gordillo R. Comparative study of carotenoid composition in three mexican varieties of Capsicum annuum L. Food Chem 2005;90:109-14.
- Jagadeesh B, Prabha T, Srinivasan K. Improved shelf life of bell capsicum fruits by manipulation of the activities of glycosidases through heat treatment. Indian J Plant Physiol 2004;9:164-8.
- Kalyani G, Ashok P, Taranalli A, Ramesh C, Krishna V, Swamy AV. Anti-inflammatory and in vitro antioxidant activity of Desmodium triquetrum (L.). Indian J Pharm 2011;43:740.
- Kurian GA, Suryanarayanan S, Raman A, Padikkala J. Antioxidant effects of ethyl acetate extract of Desmodium gangeticum root on myocardial ischemia reperfusion injury in rat hearts. Chin Med 2010;5:1-7.
- Kurian GA, Paddikkala J. Administration of aqueous extract of Desmodium gangeticum (L) root protects rat heart against ischemic reperfusion injury induced oxidative stress. Indian J Exp Biol 2009;47:129-35.
- Kurian GA, Philip S, Varghese T. Effect of aqueous extract of the Desmodium gangeticum DC root in the severity of myocardial infarction. J Ethnopharmacol 2005;97:457-61.
- Blois M S. Antioxidant determinations by the use of a stable free radical. Nature 1958;181:1199-200.
- Chandler S, Dodds J. The effect of phosphate, nitrogen and sucrose on the production of phenolics and solasodine in callus cultures of Solanum laciniatum. Plant Cell Report 1983;2:205-8.
- Delahaye C, Rainford L, Nicholson A, Mitchell S, Lindo J, Ahmad M. Antibacterial and antifungal analysis of crude extracts from the leaves of Callistemon viminalis. J Med Biol Sci 2009;3:1-7.
- Ba-Abbad MM, Kadhum AA, Mohamad AB, Takriff MS, Sopian K. Synthesis and catalytic activity of tio 2 nanocrystals for photochemical oxidation of concentrated chlorophenols under direct solar radiation. Int J Electrochem Sci 2102;7:4871-88.
- Vijayalakshmi R, Rajendran V. Synthesis and characterization of nano-TiO 2 via different methods. Arch Applied Sci Res 2012;4:1183-90.
- Zhang H, Chen G. Potent antibacterial activities of Ag/TiO2 nanocomposite powders synthesized by a one-pot sol−gel method. Environ Sci Technol 2009;43:2905-10.
- Holt KB, Bard AJ. Interaction of silver (I) ions with the respiratory chain of Escherichia coli: an electrochemical and scanning electrochemical microscopy study of the antimicrobial mechanism of micromolar Ag+. Biochem 2005;44:13214-23.